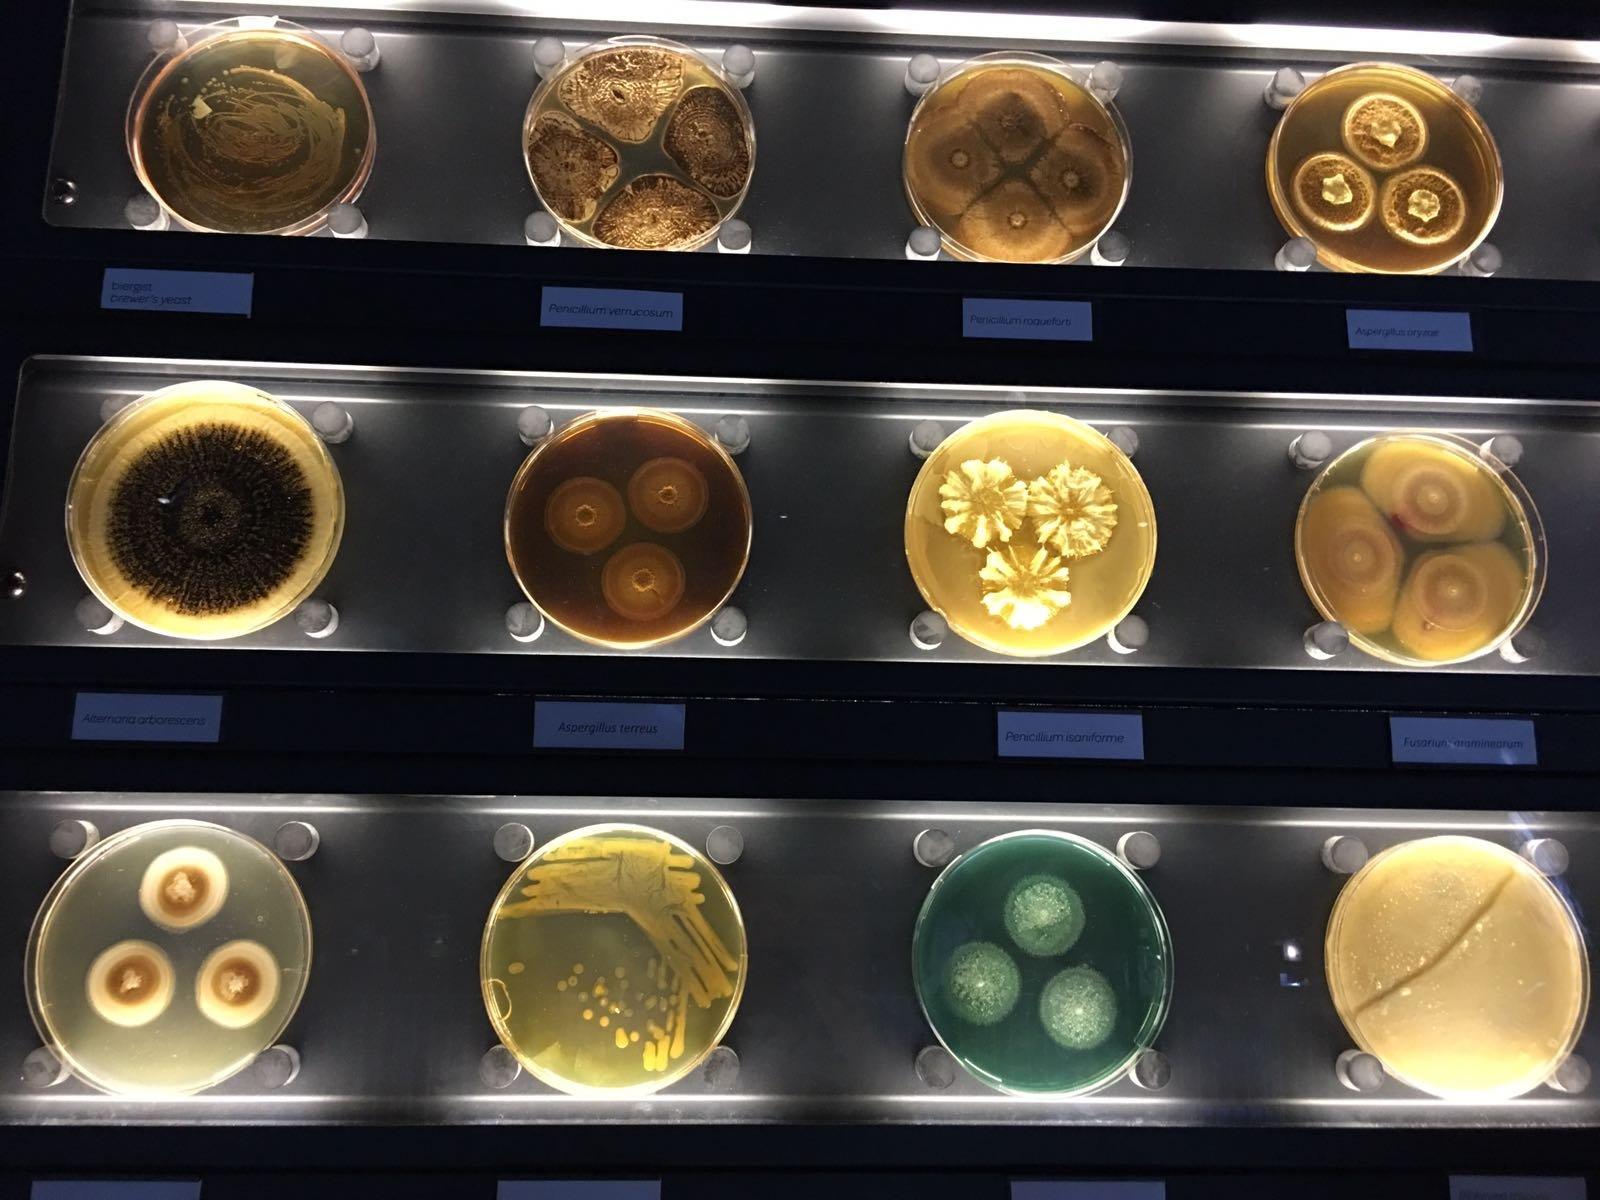
Artis Micropia

Haunting to say the least. Cleverly designed. Each brick holds the details of a fallen soul, murdere...
National Holocaust Memorial
(9)
Advertisement
Photos
Het Nationaal Holocaust Namenmonument in Amsterdam herdenkt 102.000 Nederlandse burgers die het leven hebben verloren tijdens de Holocaust. Het monument is ontworpen met zorg, waarbij elke steen de details van een vermoorde ziel bevat. Dit indrukwekkende monument biedt een plek voor bezinning en herinnering.
Bezoekers kunnen gebruik maken van audiogidsen die beschikbaar zijn in het Nederlands en het Engels. Het monument is een eerbetoon aan de slachtoffers en nodigt uit tot reflectie over hun leven en de impact van de Holocaust. Het is een plek waar men kan leren en herinneren.
Generated from the web
Also at this address
Reviews
Lizkor. To remember. The National Holocaust Namenmonument bears the names of 102,000 Dutch citizens...
You might also like
Advertisement